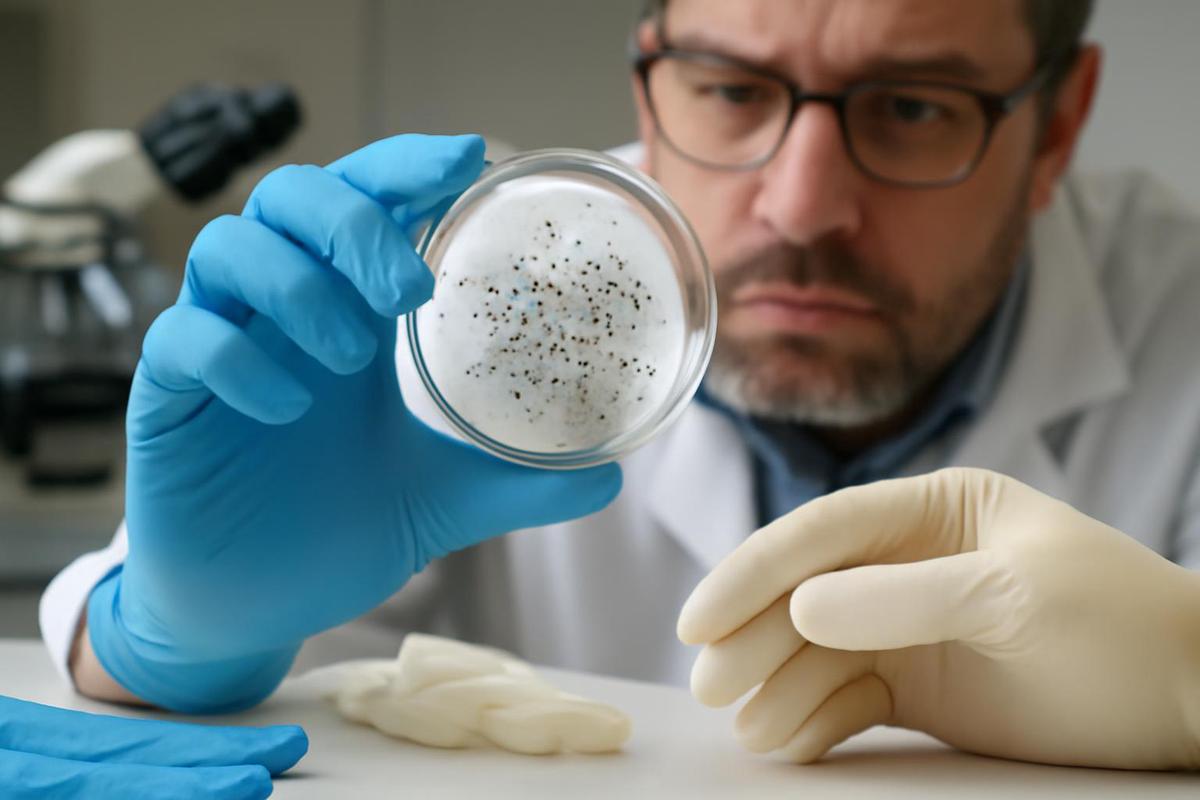

Guantes de laboratorio inflan datos sobre microplásticos, revela estudio
Un estudio de la Universidad de Michigan revela que los guantes de nitrilo y látex liberan partículas que pueden contaminar muestras y exagerar los niveles de microplásticos en el medio ambiente.
31/03/2026 | 08:16Redacción Cadena 3
Un reciente estudio de la Universidad de Michigan sorprendió a la comunidad científica al señalar que los guantes de laboratorio, comúnmente utilizados por los investigadores, podrían estar inflando las estimaciones de contaminación por microplásticos. Según la investigación, los guantes de nitrilo y látex liberan pequeñas partículas denominadas estearatos, que pueden confundirse con microplásticos durante el análisis de muestras ambientales.
Los investigadores descubrieron que estos guantes pueden transferir involuntariamente partículas a las herramientas de laboratorio utilizadas para analizar el aire, el agua y otros tipos de muestras. La contaminación generada por los estearatos, que no son plásticos, puede provocar resultados falsos positivos en las pruebas de microplásticos, llevando a los científicos a detectar partículas que no son verdaderos microplásticos. Para mitigar este problema, las investigadoras Madeline Clough y Anne McNeil recomendaron el uso de guantes de sala limpia, que liberan una cantidad significativamente menor de partículas.
Los estearatos son sustancias basadas en sales, similares a jabones, que se añaden a los guantes desechables para facilitar su separación de los moldes durante el proceso de fabricación. Sin embargo, su similitud química con ciertos plásticos complica su distinción en los análisis de laboratorio, aumentando el riesgo de obtener resultados exagerados en los estudios sobre contaminación por microplásticos.
A pesar de esta problemática, las investigadoras subrayaron que esto no significa que los microplásticos no sean un problema real. McNeil, autora principal del estudio y profesora de química en la Universidad de Michigan, afirmó: "Podríamos estar sobrestimando los microplásticos, pero debería haber ninguno". A lo que Clough agregó: "Como investigadoras de microplásticos, buscamos la aguja en el pajar, pero en realidad no debería haber una aguja para comenzar".
El estudio, liderado por Clough, quien recientemente obtuvo su doctorado, fue publicado en la revista RSC Analytical Methods y recibió apoyo de la Iniciativa de Investigación Meet the Moment de la U-M College of Literature, Science, and the Arts.
Un descubrimiento inesperado detrás de resultados inflados
La investigación comenzó durante un proyecto colaborativo que examinaba los microplásticos en el aire en Michigan. Este esfuerzo involucró a investigadores de múltiples departamentos de la U-M, incluyendo Química, Estadística y Ciencias de la Tierra y del Espacio. Clough y McNeil trabajaron con colaboradores como el profesor de química Andy Ault y estudiantes de posgrado Rebecca Parham y Abbygail Ayala para recolectar muestras de aire.
Para capturar partículas, el equipo utilizó muestreadores de aire equipados con superficies metálicas que recolectan material del ambiente. Estas muestras fueron luego analizadas mediante espectroscopía basada en luz para identificar los tipos de partículas presentes. Al preparar las superficies de muestreo, Clough siguió la práctica estándar y usó guantes de nitrilo. Sin embargo, al revisar los resultados, el número de microplásticos detectados fue miles de veces mayor de lo esperado.
Clough comentó: "Esto llevó a una búsqueda frenética para determinar de dónde podría provenir esta contaminación, porque sabíamos que este número era demasiado alto para ser correcto". A lo largo del proceso de investigación, se consideraron varias fuentes de contaminación, hasta que finalmente se rastreó hasta los guantes.
Investigación sobre cómo los guantes afectan los datos de microplásticos
Para investigar más a fondo, los investigadores probaron siete tipos diferentes de guantes, incluidos los de nitrilo, látex y sala limpia, junto con métodos comúnmente utilizados para identificar microplásticos. Sus experimentos recrearon condiciones típicas de laboratorio, como el contacto de una mano con guantes sobre filtros, portaobjetos y otros equipos usados durante el análisis. Estas interacciones rutinarias transfirieron partículas de los guantes a las superficies de prueba.
En promedio, los guantes introdujeron alrededor de 2,000 señales de falsos positivos por milímetro cuadrado. Clough explicó: "El tipo de contacto que intentamos imitar abarca todas las variedades de investigación sobre microplásticos. Si se contacta una muestra con una mano enguantada, es probable que se impartan estos estearatos que podrían sobreestimar sus resultados". Los guantes de sala limpia demostraron un rendimiento significativamente mejor, liberando muchas menos partículas, probablemente porque están fabricados sin recubrimientos de estearato y están destinados a su uso en entornos altamente controlados.
Distinguiendo microplásticos reales de falsos positivos
El equipo también exploró si es posible distinguir visualmente los microplásticos reales de las partículas de estearato. Utilizando microscopía electrónica de barrido y microscopía basada en luz, encontraron que los estearatos lucen casi idénticos al polietileno, un plástico común. A pesar de este desafío, Clough y McNeil, junto con el estudiante de posgrado Eduardo Ochoa Rivera y el profesor de estadística Ambuj Tewari, desarrollaron métodos para separar los microplásticos verdaderos de la contaminación relacionada con los guantes. Estas técnicas podrían permitir a los científicos revisar conjuntos de datos anteriores y producir estimaciones más precisas.
Clough concluyó: "Para los investigadores de microplásticos que tienen conjuntos de datos afectados, aún hay esperanza para recuperarlos y encontrar una cantidad verdadera de microplásticos". Los hallazgos resaltan la importancia de la experiencia química en la investigación de microplásticos, especialmente en lo que respecta a la identificación de diferencias sutiles entre materiales.
McNeil agregó: "Este campo es muy desafiante, porque hay plástico por todas partes. Pero por eso necesitamos químicos y personas que comprendan la estructura química para trabajar en este campo".
Lectura rápida
¿Qué descubrieron los investigadores?
Encontraron que los guantes de nitrilo y látex liberan estearatos que pueden contaminar muestras y exagerar los niveles de microplásticos.
¿Quién realizó el estudio?
El estudio fue llevado a cabo por investigadores de la Universidad de Michigan, incluyendo a Madeline Clough y Anne McNeil.
¿Cuándo se publicó el estudio?
El estudio fue publicado el 29 de marzo de 2026.
¿Dónde se llevó a cabo la investigación?
La investigación se realizó en Michigan y abarcó múltiples departamentos de la U-M.
¿Por qué es importante este descubrimiento?
Este hallazgo es crucial ya que podría llevar a sobreestimaciones en los datos sobre microplásticos, afectando la comprensión del problema ambiental.